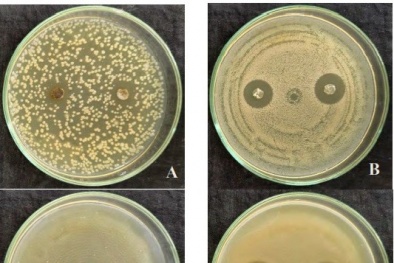
Sáng chế màng trị bỏng làm nhanh liền vết thương

Trang chủ

Luật Chuyển đổi số thúc đẩy phát triển đất nước trong kỷ nguyên số
(VietQ.vn) - Luật Chuyển đổi số không chỉ giải quyết bài toán công nghệ, mà quan trọng hơn là tạo ra động lực cải cách thể chế, đổi mới quản trị và thúc đẩy phát triển đất nước trong kỷ nguyên số.
-

4 hoạt động nhằm mở rộng diện bao phủ BHXH tự nguyện
Thị trường collagen giả thật lẫn lộn, chuyên gia cảnh báo gì?
Đi làm cả năm, Tết này bạn mang gì về cho cha mẹ?
Hệ thống cửa hàng Urban Store: Quần áo không chứng nhận, có an toàn cho sức khoẻ người dùng?
Nâng cao chất lượng nguồn nhân lực, tạo bứt phá về năng suất lao động
Bán thuốc bảo vệ thực vật trái phép, chủ cửa hàng bị phạt gần 80 triệu đồng
Một số ‘điểm sáng’ của nền kinh tế Việt Nam trong năm 2022
-
Chuyển đổi số quốc gia: Hiện thực hóa tầm nhìn kinh tế số, xã hội số
-

Xác lập mô hình tăng trưởng mới, đưa đất nước phát triển giàu mạnh
Tin mới 24h
Sáng chế màng trị bỏng làm nhanh liền vết thương
(VietQ.vn) - TS. Phan Mỹ Hạnh và cộng sự tại Trung tâm Công nghệ sinh học TP.HCM vừa nghiên cứu chế tạo thành công màng trị bỏng từ cellulose vi khuẩn tẩm thuốc nhả chậm giúp làm liền vết thương mà ít gây đau đớn cho người bệnh.

Khảo sát, đánh giá mức độ hài lòng và biện pháp cải tiến đối với hoạt động giải quyết TTHC của Tổng cục TCĐLCL
(VietQ.vn) - Nhằm khảo sát, đánh giá mức độ hài lòng của các cá nhân, tổ chức đối với việc giải quyết thủ tục hành chính (TTHC) của Tổng cục Tiêu chuẩn Đo lường Chất lượng (TCĐLCL) để có cơ sở đề xuất các biện pháp nâng cao hoạt động giải quyết TTHC, Tổng cục trưởng Tổng cục TCĐLCL đã ban hành Quyết định số 1014/QĐ-TTg ngày 16/6/2022 phê duyệt nhiệm vụ khoa học công nghệ cấp cơ sở thực hiện năm 2022 “Nghiên cứu khảo sát, đánh giá mức độ hài lòng của các cá nhân, tổ chức để đưa ra các biện pháp cải tiến đối với hoạt động giải quyết thủ tục hành chính của Tổng cục Tiêu chuẩn Đo lường Chất lượng”.

Mẫu xe giá rẻ dành cho gia đình như MPV Stargazer có gì đặc biệt?
(VietQ.vn) - Khách hàng Việt Nam luôn đặt rất nhiều kì vọng vào một sản phẩm mua về, đặc biệt là với những sản phẩm có giá trị cao như xe ô tô. Vậy nhưng thực sự thì người tiêu dùng cần gì ở một mẫu xe MPV giá rẻ dành cho gia đình như Hyundai Stargazer?

Khởi đăng loạt bài: Vạch trần ổ nhóm buôn tem dán làm nhôm thanh giả
(VietQ.vn) - Suốt nhiều tháng, nhóm PV đã lần lượt tiếp cận các đầu mối buôn tem giả bán cho các nơi có nhu cầu làm giả nhôm thanh định hình chuyên dùng trong xây dựng nhà cửa. Các đầu mối này hoạt động từ Bắc tới Nam với nhiều “đại lý phân phối” khác nhau nhưng đều có chung 1 tổng kho tại Hà Nội.

5 thương hiệu ô tô nổi tiếng có phí bảo dưỡng rẻ nhất
(VietQ.vn) - Bảo dưỡng xe là điều mà mọi tài xế đều quan tâm khi điều khiển ô tô, dưới đây là những hãng xe luôn đảm bảo mức chi phí bảo dưỡng xe ổn định.

Chuyên gia chỉ cách phân biệt yến sào thật, yến sào giả khi mua dịp Tết
(VietQ.vn) - Ngày Tết, nhiều người thường biếu tặng nhau yến sào. Tuy nhiên, trên thị trường hiện bán rất nhiều loại có cả thật và giả. Vậy làm thế nào để phân biệt yến sào thật, yến sào có chất lượng?

Toyota Avanza Premio 2023 giá 588 triệu đồng đáng cân nhắc để mua đi chơi Tết
(VietQ.vn) - Toyota Avanza Premio 2023 là mẫu xe ô tô áp dụng cấu trúc khung gầm dựa trên nền tảng DNGA toàn cầu. Theo đó là sự thay đổi hệ dẫn động cầu trước, hướng đến tối ưu chi phí vận hành.

Nghiêm túc kiểm soát giấy tờ tùy thân của khách ở cửa ra máy bay
(VietQ.vn) - Cục Hàng không Việt Nam vừa yêu cầu Cảng Hàng không quốc tế Tân Sơn Nhất và các đơn vị thực hiện nghiêm việc kiểm soát giấy tờ tùy thân của hành khách tại cửa ra máy bay.
.













